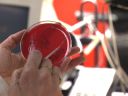
VMB101

| Medical -Laboratory
(V-Line) Professionals & their equipment in pathology, pharmacology, & other medical sciences ˇ@ |
Number of Clips: 34 |
||
|
|
|
| ||||||||||||||||||||||||||||||||||||||||||||||||||||
|
|
|
| ||||||||||||||||||||||||||||||||||||||||||||||||||||
|
|
|
| ||||||||||||||||||||||||||||||||||||||||||||||||||||
|
|
|
| ||||||||||||||||||||||||||||||||||||||||||||||||||||
|
|
|
| ||||||||||||||||||||||||||||||||||||||||||||||||||||
|
| ||||||||||||||||||||||||||||||||||||||||||||||||||||||
ˇ@
ˇ@